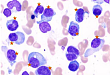

-
-
2021.05.07 胡凯专栏丨追击多发性骨髓瘤终极难题:复发难治进展期浆细胞白血病
多发性骨髓瘤(multiple myeloma,MM) 是血液系统第二大恶性肿瘤,好发于老年人,其特征为恶性浆细胞不可控的进展性增生。该病可降低患者对感染的抵抗力,造成严重骨病(伴有骨痛、病理性骨折和
-

-
2021.04.06 髌骨软化症,用 PRP 治疗效果怎么样?
髌骨软化症是髌骨软骨软化症的简称,是以膝关节髌骨软骨因劳损、创伤引起退变、变性为病理特征的疾病,临床表现为软骨磨损、破裂甚至软骨脱落,主要症状是膝关节疼痛、跛行,特别是上、下楼困难,深蹲困难等。按压膝
-

-
2021.01.12 当带状疱疹病毒遇上艾滋病毒,将会出现什么样的叠加效应?
艾滋病,病原体为人类免疫缺陷病毒(HIV),病毒感染人体后主要侵犯免疫系统,包括 CD4+T 淋巴细胞、单核巨噬细胞和树突状细胞等
-

-
2020.12.31 潜在杀手:HIV 相关隐球菌性脑膜炎
隐球菌病是由隐球菌引起的机会性感染,与获得性免疫缺陷综合征(AIDS)密切相关。隐球菌属包括17个种和18个变种,其中新生隐球菌是本病最主要的病原菌。隐球菌性脑膜炎...
-

-
2020.08.21 单克隆抗体、小分子激酶抑制剂和细胞治疗诱发感染?
近年来,化疗、免疫调剂治疗、造血干细胞移植和固体器官移植的出现已彻底改变了恶性肿瘤、自身免疫性疾病和终末期器官衰竭患者的管理
-

-
2019.10.25 新华医院消化团队打造|乙肝抗病毒治疗典型病例深度解析
从大量的临床病例入手,深度解析乙型肝炎抗病毒治疗的前因后果。
-

-
2019.10.16 研究生备考时间紧任务重,如何高效备战逆袭上岸?
系统高效的学习方法,助你少走弯路!
-

-
2019.09.19 关于房颤,你必须要知道的几件事。
房颤发病率呈急剧上升趋势,其发病率的增长速度超过了心肌梗死和心力衰竭等疾病,已经成为影响居民健康水平提高、阻碍社会经济发展的重大公共卫生问题。
-

-
2019.09.11 中国手术部位感染预防指南概要
中国版手术部位感染(surgical site infection,SSI)于近期发布,与 2010 年我国卫健委发布的《外科手术部位感染预防与控制技术指南(试行)》相隔 9 年之久
-

-
2019.09.09 困惑 | 如何才能触达「院内血糖管理」认知盲区?
近年来,随着糖尿病患者人数的迅猛上升,入院患者也随之激增,在我国大型医院住院患者中,糖尿病已经成为继高血压之后的第二大慢性病。与此同时,糖尿病住院患者具有平...
- os
- os
